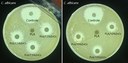
Antimicrobiano.tif

Notícias
Pesquisa Paraíba
Governo da Paraíba investe em pesquisas de Biomateriais para uso em Saúde
Pesquisadores da Universidade Federal de Campina Grande (UFCG) desenvolveram biomateriais para uso em saúde, com resultados relevantes e inovadores: na confecção de cimentos inorgânicos para fins de regeneração óssea; desenvolvimento de materiais com ação antimicrobiana para fins de tratamento de feridas e regeneração óssea; e uso de sistemas à base de quitosana para tratamento de feridas.
O material é resultado de pesquisas desenvolvidas a partir da consolidação do Núcleo de Excelência em Desenvolvimento de Biomateriais para Uso em Saúde, com o aporte de R$ 300 mil do Governo da Paraíba, por meio de edital da Fundação de Apoio à Pesquisa da Paraíba (Fapesq) e apoio da Secretaria de Estado da Ciência, Tecnologia, Inovação e Ensino Superior (Secties).
O desenvolvimento das atividades e pesquisas nesses eixos vem se concentrando no Laboratório de Avaliação e Desenvolvimento de Biomateriais do Nordeste (CERTBIO – UFCG) e no Laboratório de Tecnologia dos Materiais (LTM – UFCG), com a participação de nove pesquisadores. Entre os materiais desenvolvidos estão: Membrana de quitosana com nanofibras de vidros bioativos para liberação de íons terapêuticos, Hidrogel com fibras para liberação controlada de fármacos e Membranas com ação antimicrobiana.
De acordo com o coordenador do projeto, Dr. Romualdo Rodrigues Menezes, o desenvolvimento dos biomateriais tornou-se nos últimos anos um dos novos horizontes da ciência e tecnologia de materiais, com enorme potencial econômico e social. No entanto, a consolidação desse potencial tecnológico e comercial, notadamente no Brasil, enfrenta limitações associadas ao elevado custo de alguns métodos de produção e, principalmente, a falta de tecnologias, pesquisas e expertise necessários para sua aplicação comercial a um custo condizente com a realidade nacional.
“Vindo ao encontro dessa demanda social, este projeto teve por objetivo a consolidação de um núcleo de excelência no desenvolvimento de biomateriais para uso em saúde. Para tanto, foram reunidos pesquisadores com conhecimentos em biomateriais e caracterização de materiais, de modo a criar uma equipe multidisciplinar com expertise em desenvolvimento de biomateriais (poliméricos e cerâmicos), a fim de poder executar de forma eficiente e exitosa o desafio proposto neste projeto, que é a criação de um Núcleo de Excelência em Desenvolvimento de Biomateriais para Uso em Saúde; e elencados três eixos de execução da pesquisa, onde buscar-se-á confecção de cimentos inorgânicos para fins de regeneração óssea, desenvolvimento de materiais com ação antimicrobiana para fins de tratamento de feridas e regeneração óssea e uso de sistemas à base de quitosana para tratamento de feridas, caracterizando-se como uma pesquisa tecnológica na fronteira do conhecimento da ciência e engenharia de materiais”, explicou ele.
Vêm sendo produzidos cimentos inorgânicos de aluminatos de cálcio e avaliado seu potencial para fins de regeneração óssea; produzidos vidros bioativos e avaliada sua bioatividade e potencial antimicrobiano; produzidos scaffolds e membranas híbridos contendo íons inorgânicos terapêuticos, e avaliado seu potencial antimicrobiano; desenvolvido sistemas de liberação controlada e avaliado suas taxas de liberação; e desenvolvido sistemas a base de quitosana, para fins de tratamento de feridas e úlceras.
“Os resultados obtidos vêm sendo promissores nos ensaios in vitro e são importantes para o desenvolvimento do estado porque busca estimular o desenvolvimento regional e nacional em uma área estratégica, gerar conhecimento científico em um setor de importância social e econômica e atender a uma demanda tanto da sociedade como do setor público e sistema de saúde, além de buscar contribuir no desenvolvimento social, científico e tecnológico do Estado da Paraíba”, enfatizou Romualdo.
Participam das pesquisas:
Dr. Romualdo Rodrigues Menezes, Dr. Marcus Vinicius Lia Fook, Dr.a Suedina Maria de Lima Silva, Dr. Hugo Alexandre de Oliveira Rocha, Dr.a. Rayssa de Sousa Victor, M.Sc. Mairly Karolyne da Silva Souza, M.Sc. Maria Eduarda Barbosa Araújo, M.Sc. Wennya Joyce Carneiro Rodrigues Ramalho e Keila da Conceição Costa.